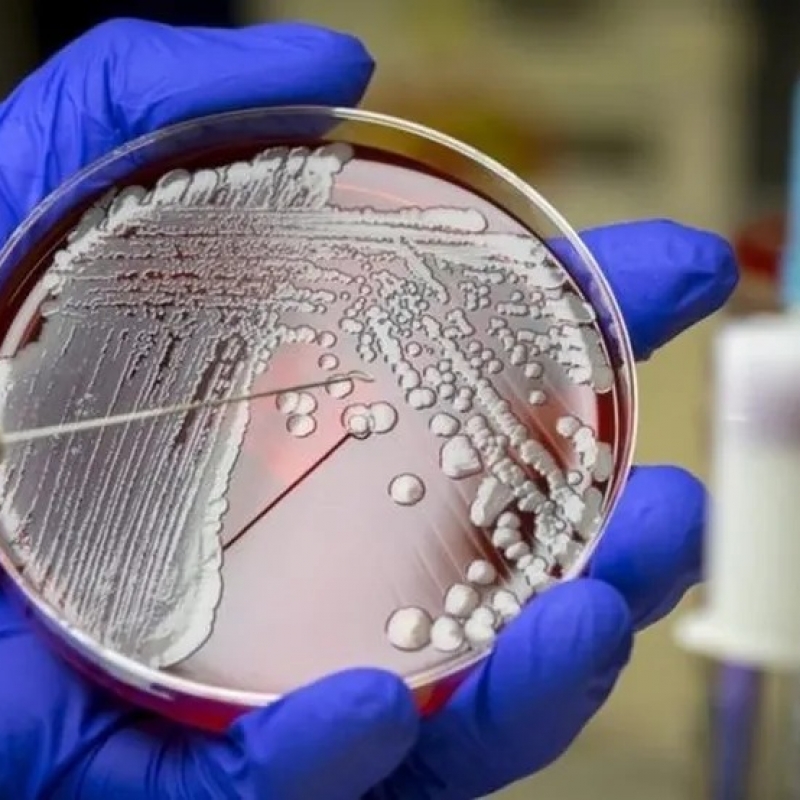

SAÚDE | A droga é capaz de atacar uma das três superbactérias mais perigosas, segundo os pesquisadores.
Cientistas usaram inteligência artificial (IA) para desenvolver um novo antibiótico capaz de matar uma espécie mortal de superbactéria.
A tecnologia ajudou a filtrar uma lista de milhares de compostos químicos em potencial, reduzindo-os a apenas alguns que poderiam ser testados em laboratório.
É o exemplo mais recente de como ferramentas de IA podem ser uma força revolucionária na ciência e na medicina.
Para deter as superbactérias
Os antibióticos matam as bactérias. Mas existe uma escassez de novos medicamentos há décadas — e as bactérias estão se tornando mais difíceis de tratar, à medida que desenvolvem resistência aos antibióticos que temos disponíveis.
Estima-se que mais de um milhão de pessoas morram por ano de infecções resistentes ao tratamento com antibióticos.
Os pesquisadores se concentraram em uma das espécies mais problemáticas de bactéria — a Acinetobacter baumannii, que pode infectar feridas e causar pneumonia.
Você pode não ter ouvido falar dela, mas é uma das três superbactérias que a Organização Mundial da Saúde (OMS) identificou como uma ameaça "crítica".
Muitas vezes, é capaz de ignorar vários antibióticos — e é um problema em hospitais e casas de repouso, onde pode sobreviver em superfícies e equipamentos médicos.
Jonathan Stokes, da Universidade McMaster, no Canadá, descreve a bactéria como o "inimigo público número um", uma vez que é "muito comum" encontrar casos em que é "resistente a quase todos os antibióticos".
Cientistas usaram inteligência artificial (IA) para desenvolver um novo antibiótico capaz de matar uma espécie mortal de superbactéria.
A tecnologia ajudou a filtrar uma lista de milhares de compostos químicos em potencial, reduzindo-os a apenas alguns que poderiam ser testados em laboratório.
O resultado foi um potente antibiótico experimental chamado abaucina, que vai precisar passar por mais testes antes de ser usado.
Os pesquisadores, do Canadá e dos EUA, dizem que a IA tem o poder de acelerar consideravelmente a descoberta de novos medicamentos.É o exemplo mais recente de como ferramentas de IA podem ser uma força revolucionária na ciência e na medicina.
Para deter as superbactérias
Os antibióticos matam as bactérias. Mas existe uma escassez de novos medicamentos há décadas — e as bactérias estão se tornando mais difíceis de tratar, à medida que desenvolvem resistência aos antibióticos que temos disponíveis.
Estima-se que mais de um milhão de pessoas morram por ano de infecções resistentes ao tratamento com antibióticos.
Os pesquisadores se concentraram em uma das espécies mais problemáticas de bactéria — a Acinetobacter baumannii, que pode infectar feridas e causar pneumonia.
Você pode não ter ouvido falar dela, mas é uma das três superbactérias que a Organização Mundial da Saúde (OMS) identificou como uma ameaça "crítica".
Muitas vezes, é capaz de ignorar vários antibióticos — e é um problema em hospitais e casas de repouso, onde pode sobreviver em superfícies e equipamentos médicos.
Jonathan Stokes, da Universidade McMaster, no Canadá, descreve a bactéria como o "inimigo público número um", uma vez que é "muito comum" encontrar casos em que é "resistente a quase todos os antibióticos".